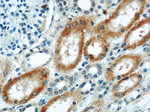
ABLIM2 Antibody in Immunohistochemistry (Paraffin) (IHC (P))

Search
Proteintech
ABLIM2 Polyclonal Antibody
{{$productOrderCtrl.translations['antibody.pdp.commerceCard.promotion.promotions']}}
{{$productOrderCtrl.translations['antibody.pdp.commerceCard.promotion.viewpromo']}}
{{$productOrderCtrl.translations['antibody.pdp.commerceCard.promotion.promocode']}}: {{promo.promoCode}} {{promo.promoTitle}} {{promo.promoDescription}}. {{$productOrderCtrl.translations['antibody.pdp.commerceCard.promotion.learnmore']}}
产品信息
22433-1-AP
种属反应
宿主/亚型
分类
类型
抗原
偶联物
形式
浓度
规格
纯化类型
保存液
内含物
保存条件
运输条件
产品详细信息
Immunogen sequence: SIISVPASS TSGSPSRVIY AKLGGEILDY RDLAALPKSK AIYDIDRPDM ISYSPYISHS AGDRQSYGEG DQDDRSYKQC RTSSPSSTGS VSLGRYTPTS RSPQHYSRP (282-389 aa encoded by BC122567)
靶标信息
ABLIM2 (Actin Binding LIM Protein Family Member 2) is a Protein Coding gene. Among its related pathways areDevelopmental BiologyandAxon guidance. Gene Ontology (GO) annotations related to this gene includeactin binding. An important paralog of this gene isABLIM1.
仅用于科研。不用于诊断过程。未经明确授权不得转售。
篇参考文献 (0)
生物信息学
蛋白别名: abLIM-2; Actin-binding LIM protein 2; Actin-binding LIM protein family member 2; testis tissue sperm-binding protein Li 35a; unnamed protein product
基因别名: ABLIM2; AI606905; C230091L11; KIAA1808
UniProt ID: (Human) Q6H8Q1, (Mouse) Q8BL65, (Rat) Q6KC51
Entrez Gene ID: (Human) 84448, (Mouse) 231148, (Rat) 360958